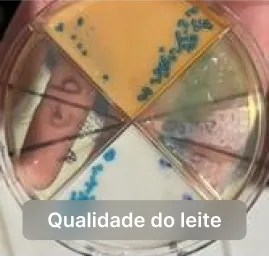

A plataforma ideal para capacitação em pecuária de leite.

os índices de produção da sua fazenda.
com o melhor conhecimento disponível.
da concorrência com conhecimento técnico.
Garantir a sustentabilidade da sua produção.
novas tecnologias e técnicas de manejo.
no setor de pecuária.
sem aumentar os custos.
e aumentar o sucesso nas suas decisões.

Não há tempo a perder na pecuária de leite. Com a Cowflix, você
tem acesso ao conhecimento dos maiores especialistas, em uma
plataforma moderna e dinâmica, disponível onde e quando você
precisar.
O formato das aulas, a variedade de assuntos, quantidade de aulas,
a experiência intuitiva do usuário na plataforma e a qualidade do
conteúdo diferenciam a Cowflix de tudo o que existe no mercado.
Explore todo nosso acervo, com mais de 200 vídeos divididos em categorias como:

O valor real desse conteúdo, se fosse vendido separadamente, tranquilamente seria superior a R$4.000,00. Mas hoje, você tem acesso a tudo isso por um valor especial. Na verdade, você não vai pagar nem um quarto desse valor.
Sendo bem sincero contigo, o que vamos te apresentar aqui, é algo único, e não sei se irá se repetir


Porque o meu objetivo aqui não é o dinheiro. Como já compartilhei ao longo desta jornada, financeiramente, eu e minha equipe já alcançamos o que precisávamos para viver com conforto e tranquilidade. Estou oferecendo o acesso à Cowflix porque quero, em poucos meses, ouvir de você como transformou sua produção e a produtividade do seu rebanho. Quero saber como você aplicou o conhecimento e conquistou a excelência que sempre desejou na pecuária de leite. É isso que realmente me motiva. Quando ajudo produtores e profissionais do campo a alcançarem seus objetivos, a melhorarem seus processos e a prosperarem, eu sinto que cumpro minha missão. E isso, para mim, é algo que vai além de qualquer valor financeiro. Eu já estive no seu lugar, sei exatamente os desafios que você enfrenta no campo. Eu entendo suas dificuldades
Comprometimento.
Quando investimos financeiramente em algo, nosso comprometimento aumenta. O valor que você paga é um incentivo para que você realmente se dedique ao conteúdo. Quantas vezes já tivemos acesso a materiais gratuitos e deixamos de lado por falta de envolvimento? Aqui na Cowflix, eu quero que você aproveite ao máximo todos os vídeos e aulas disponíveis, que reveja os conteúdos quantas vezes forem necessárias, aplicando-os de forma prática e imediata em sua produção.
Equipe e qualidade.
Produzir conteúdos técnicos de alta qualidade, editar vídeos profissionais, manter uma equipe especializada e oferecer suporte ativo tem um custo significativo. Para garantir que a Cowflix continue evoluindo e oferecendo o melhor conteúdo para você, é essencial que eu honre esses compromissos e reinvista constantemente no desenvolvimento de novas aulas e funcionalidades.

Esta garantia permite que você, dentro de 7 dias corridos a partir da data de inscrição, decida se o curso atende às suas expectativas.


Carla é Médica Veterinária formada na UNESP Botucatu, possui Mestrado em Medicina Veterinária Preventiva pela UNESP Jaboticabal e Doutorado em Doenças Tropicais pela Faculdade de Medicina Unesp Botucatu. Atualmente é Sócia e Responsável Técnica do VIDAVET Laboratório de Análises Veterinárias Ltda e da Innovate Science. Atuou na área Acadêmica por 6 anos, como professora assistente na disciplina de Doenças Infecciosas dos Animais na Universidade Santo Amaro - UNISA e Universidade Bandeirantes - UNIBAN. Participou de treinamento técnico na Universidade de Wisconsin nas áreas de sanidade bovina e mastite durante 1 ano. Participou de treinamento técnico no Department of Agriculture, Trade and Consumer em Madison Wisconsin por 1 ano. Participou de 28 artigos científicos publicados em periódicos nacionais e internacionais Credenciada pelo Ministério da Agricultura, Pecuária e Abastecimento - MAPA para realização de análises na Área de Diagnóstico Animal no escopo Anemia Infecciosa Equina e no Programa Nacional de Controle e Erradicação de Brucelose e Tuberculose - MAPA.
Luis Fernando Moroz atua com assistência técnica e consultoria em propriedades de leite, e é gestor operacional em uma fazenda com 1080 vacas em lactação no Paraná, desde 2014.É médico veterinário e especialista em Cliníca e Reprodução pela Universidade TUIUTI-Paraná. Possui MBA em gestão de pessoas pela FGV,e MBA em Desenvolvimento Humano de Gestores (DHG). Ministra cursos na pecuária leiteira há 7 anos, etem mais de 1500 alunos. Recentemente foi integrando ao quadro de docentesda PPGVet, em cursos de pós graduação. Integra o quadro de membros do NMC (National Mastitis Council).

Este produto não garante resultados específicos. Qualquer menção ao desempenho de uma estratégia não deve ser entendida como uma promessa de resultados. Os resultados variam de acordo com o desempenho individual, e diversos fatores pessoais podem influenciar, como a facilidade de aprendizado e a maneira de aplicação. Não é obrigatório adquirir este produto para ser um afiliado. Este curso completo oferece a oportunidade de obter uma renda extra através dessa profissão, além de aprender estratégias e receber suporte. As plataformas de trabalho como a Hotmart são acessíveis gratuitamente. Este produto não é da Hotmart, sendo apenas a plataforma utilizada para o pagamento. Este site não possui afiliação com o Facebook ou TikTok, nem com qualquer entidade dessas redes sociais. Após sair do Facebook e TikTok, a responsabilidade é inteiramente do nosso site. Esforçamo-nos para indicar claramente todas as evidências do produto e apresentar resultados reais. Não comercializamos seu e-mail ou qualquer informação a terceiros e nunca fazemos spam. Se tiver alguma dúvida, fique à vontade para entrar em contato conosco no horário comercial de segunda a sexta, das 09h00 às 18h00. Respondemos todas as mensagens conforme a ordem de chegada.